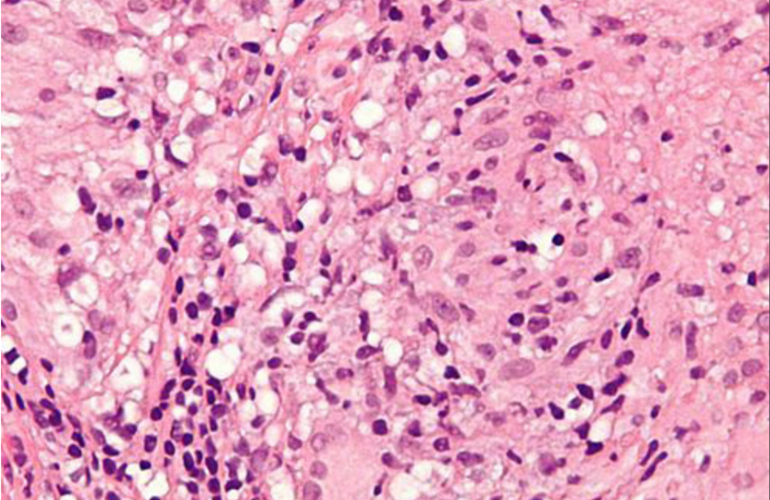

Movember werd in 2003 in Australië opgericht om geld in te zamelen voor prostaat- en teelbalkankeronderzoek. Via de VS en het Verenigd Koninkrijk bereikte de stichting ook Nederland, waar nu duizenden mannen in de maand november hun Movembersnor laten staan.


Informed Medische Animaties produceren kwalitatieve onafhankelijke 3D animaties voor alle stakeholders in de zorg!
Sinds eind 2019 is er een landelijk tekort aan BCG blaasinstillaties voor de indicatie adjuvante behandeling van blaaskanker.
Diagnostiek bij prostaatkanker heeft momenteel veel aandacht. De nieuwe keuzehulp op Thuisarts.nl ‘Testen op prostaatkanker?’ helpt mannen die hierover vragen hebben een weloverwogen keuze te maken.

De Nederlandse Vereniging voor Urologie heeft samen gewerkt aan het themanummer Man & Gezondheid wat afgelopen woensdag 20 november in de Telegraaf is gepubliceerd.

Sinds enige weken wordt er in diverse publieke kanalen aangespoord tot het individueel opsporen van prostaatkanker met behulp van een zelf-test onder de naam Mytest Prostaat van de firma Mylan .